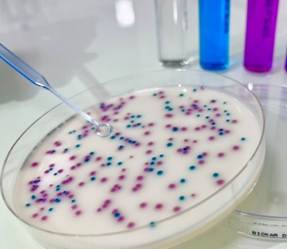

Why Salmonella Testing Matters
Salmonella remains one of the most common causes of foodborne illness worldwide. Contamination can occur at any stage of the supply chain—from raw ingredients to finished products. For food producers, retailers and laboratories, reliable Salmonella detection is critical to protecting public health, meeting regulatory standards and maintaining brand reputation.
What is Salmonella?
Salmonella is a genus of Gram-negative, rod-shaped bacteria that are among the most common causes of foodborne illness worldwide. Belonging to the Enterobacteriaceae family, these bacteria can survive in many environments and infect both humans and animals.
There are two recognized species:
- Salmonella enterica – responsible for nearly all human infections, with over 2,600 known serovars.
- Salmonella bongori – less common, typically associated with reptiles.
The serovars S. Enteritidis and S. Typhimurium are the most frequent causes of human disease globally.
How Infection Occurs
Infection (Salmonellosis) usually happens through the faecal–oral route, most often by eating contaminated food or water. Common sources include:
- Undercooked poultry, eggs, or meat
- Unpasteurized milk and dairy products
- Fresh fruits and vegetables
- Contaminated water
- Cross-contamination in kitchens and processing plants
Symptoms and Health Effects
The incubation period is typically 12–36 hours after exposure. Symptoms may include:
- Diarrhea
- Abdominal cramps
- Fever
- Nausea and vomiting
Most people recover within a week, but severe cases can lead to hospitalization. Vulnerable groups such as infants, the elderly, and immunocompromised individuals are at higher risk of complications, including bloodstream infections.
Global Impact
- Public health: Millions of cases reported worldwide each year, with significant illness and hospitalizations.
- Economy: Costly product recalls, lost productivity, and healthcare expenses.
- Food industry: Strict regulations (e.g., EU, FDA, Codex Alimentarius) require control and testing to prevent contamination.
Detection and Control
- Laboratory testing is essential to detect Salmonella in food and environmental samples. Methods include culture-based techniques, immunological tests, PCR/qPCR, and validated rapid kits.
- Prevention strategies include good agricultural and manufacturing practices, HACCP systems, vaccination in livestock, and consumer food safety education.
Challenges in Detecting Salmonella
Traditional culture methods, while reliable can be time-consuming – often taking several days for results. In today’s fast-moving food industry, delays can lead to costly recalls, production downtime and risks to consumer safety. Rapid, sensitive and validated testing solutions are now essential.
Modern Salmonella Testing Solutions
- Culture-Based Methods – The gold standard for confirmatory testing, used to isolate and identify Salmonella strains.
- Rapid Immunoassays – Simple to use, these provide quick screening results and are ideal for routine quality checks.
- Molecular Methods (PCR) – Highly sensitive and specific, PCR-based tests detect Salmonella DNA within hours, enabling faster decision-making.
- Automation & High-Throughput Platforms – Designed for laboratories processing large sample volumes, reducing manual errors and improving efficiency.
Benefits of Advanced Testing
- Faster turnaround times for release of safe products
- Higher accuracy and sensitivity compared to traditional methods
- Compliance with international food safety regulations
- Reduced risk of product recalls and reputational damage
Choosing the Right Solution
The best testing approach depends on your workflow, sample type, regulatory requirements, and throughput needs. Many organizations combine rapid screening methods with confirmatory culture techniques for both speed and accuracy.
Partnering for Food Safety
Implementing the right Salmonella testing solution strengthens consumer trust and supports compliance with global food safety standards. By adopting reliable detection methods, businesses can proactively safeguard their supply chains and contribute to a healthier, safer food system. MSC offer a range of solutions for detection and confirmation of salmonella contamination in food:
Biokar Diagnostics: Reliable Solutions for Salmonella Detection
Protecting food safety with trusted microbiology expertise
Biokar Diagnostics is a leading manufacturer of microbiological culture media and rapid detection kits, trusted by laboratories worldwide. MSC have been partnered with Biokar Diagnostics for many years.
Culture and Isolation Techniques
Compliance with standards is essential to guarantee food safety, particularly for ready-to-eat food products. Methods of detection, enumeration and serotyping of Salmonella complies with NF EN ISO 6579-1.
Enrichment of the sample is necessary, and there are two types of enrichment. Non-selective enrichment promotes the growth of all bacteria, while selective enrichment inhibits the growth of unwanted bacteria to favour Salmonella.
After enrichment, cultures are plated on solid selective culture media.
Isolated colonies obtained on these conventional media must be confirmed by biochemical testing on TSI Agar, Urea Agar and L-Lysine decarboxylation medium.
Apart from reference method, there are also alternative methods that provide numerous advantages, such as Biokar IRIS Salmonella®.
This method is AFNOR validated, for the fast detection of Salmonella spp. in all food and feed products, as well as environmental samples. It gives positive and negative screening result in just 37 hours.
IRIS Salmonella® offers multiple advantages. This easy-to-use method, with just one enrichment broth and one plate, detects Salmonella spp. including serotypes such as Typhi and Paratyphi, lactose-positive and sucrose-positive Salmonella strains, immobile serovars and monophasic strains. It offers an excellent contrast between the white agar and the pink-magenta colonies of Salmonella and the blue-green colonies of associated flora and can also detect strains with little or no esterase activity that give uncharacteristic colonies on classical media.
Microgen Path-Chek Salmonella Test
Bacteria are recovered from the surface of food manufacturing or processing equipment using a pre-moistened swab, which is capable of neutralising commonly employed detergents and sanitisers.
The sample swab is then transferred into an organism specific media (swabs have a conveniently located break point so that they can easily be broken off into the growth media).
Path-Chek® Salmonella are incubated at 35-37°C for 18-24 hours
If the specific target bacteria are present on the sample swabs, bacterial growth will cause the colour of the media to change.
Biochemical Identification
The Microgen GN-ID A from Gold Standard Diagnostics is a convenient 12 substrate ID system for the most commonly isolated Enterobacteriaceae from food samples. Obtain a reliable identification, based on its standardized biochemical substrates, easiness of use and interpretation system in 24 hours. Addition of the Microgen GN-ID B kit extends the format to a 24 substrate ID system for Enterobacteriaceae and Oxidase positive, Nonfastidious, Gram-Negative bacilli.
The Microgen rapid latex agglutination tests are the fastest, easiest and most cost-efficient methods for confirmatory identification of Salmonella colonies. The tests provide results in 2 minutes, integrate seamlessly into laboratory workflow and provide a highly specific and sensitive alternative to traditional culture methods.
Gold Standard Diagnostics BACGene GO Salmonella RT-PCR

Two Steps and Go! No more complex PCR workflows and long time to results — BACGene GO is the new standard in Food Pathogen Testing – by Gold Standard Diagnostics, a global leader in RT-PCR-based solutions for food safety and quality.
BACGene GO real-time PCR Test Kits provide materials for the qualitative detection of food pathogens from food and production environmental samples.
Short time to results due to short enrichment times (16h for Salmonella), rapid mechanical lysis (10 minutes) & a fast RT-PCR run (60 minutes).
The protocol uses a mechanical lysis with ready-to-use bead lysis tubes. The kit for 96 reactions includes RT-PCR pierceable caps so no need for opening or closing tubes, ready-to-use PCR plates with color-coded lyophilized reagents for visual check of handling, UNG enzyme included to prevent carry-over contamination & built-in positive control. AFNOR Certification and AOAC-PTM for validated performance
ELISA Solutions for the Detection of Salmonella and Listeria
ELISA assays are widely used in food pathogen detection due to their fast turnaround time, ease of use and the relatively small amount of space they take up in a laboratory. BACSpec ELISA kits enable an automated workflow using the GSD BOLTTM and Thunderbolt®, resulting in a significant reduction in the hands-on time required to run the analysis in the laboratory.
Conclusion
Salmonella is a major food safety challenge, but with the right testing solutions it can be detected quickly and reliably. By combining proven culture methods with innovative rapid technologies, laboratories and food producers can protect consumers, stay compliant, and maintain trust in their products. Choosing validated tools ensures safer supply chains — and peace of mind.
Interested in our Salmonella detection solutions?
Contact us today to learn more about how these kits and culture media can be integrated into your laboratory testing strategy.
Get In Touch

